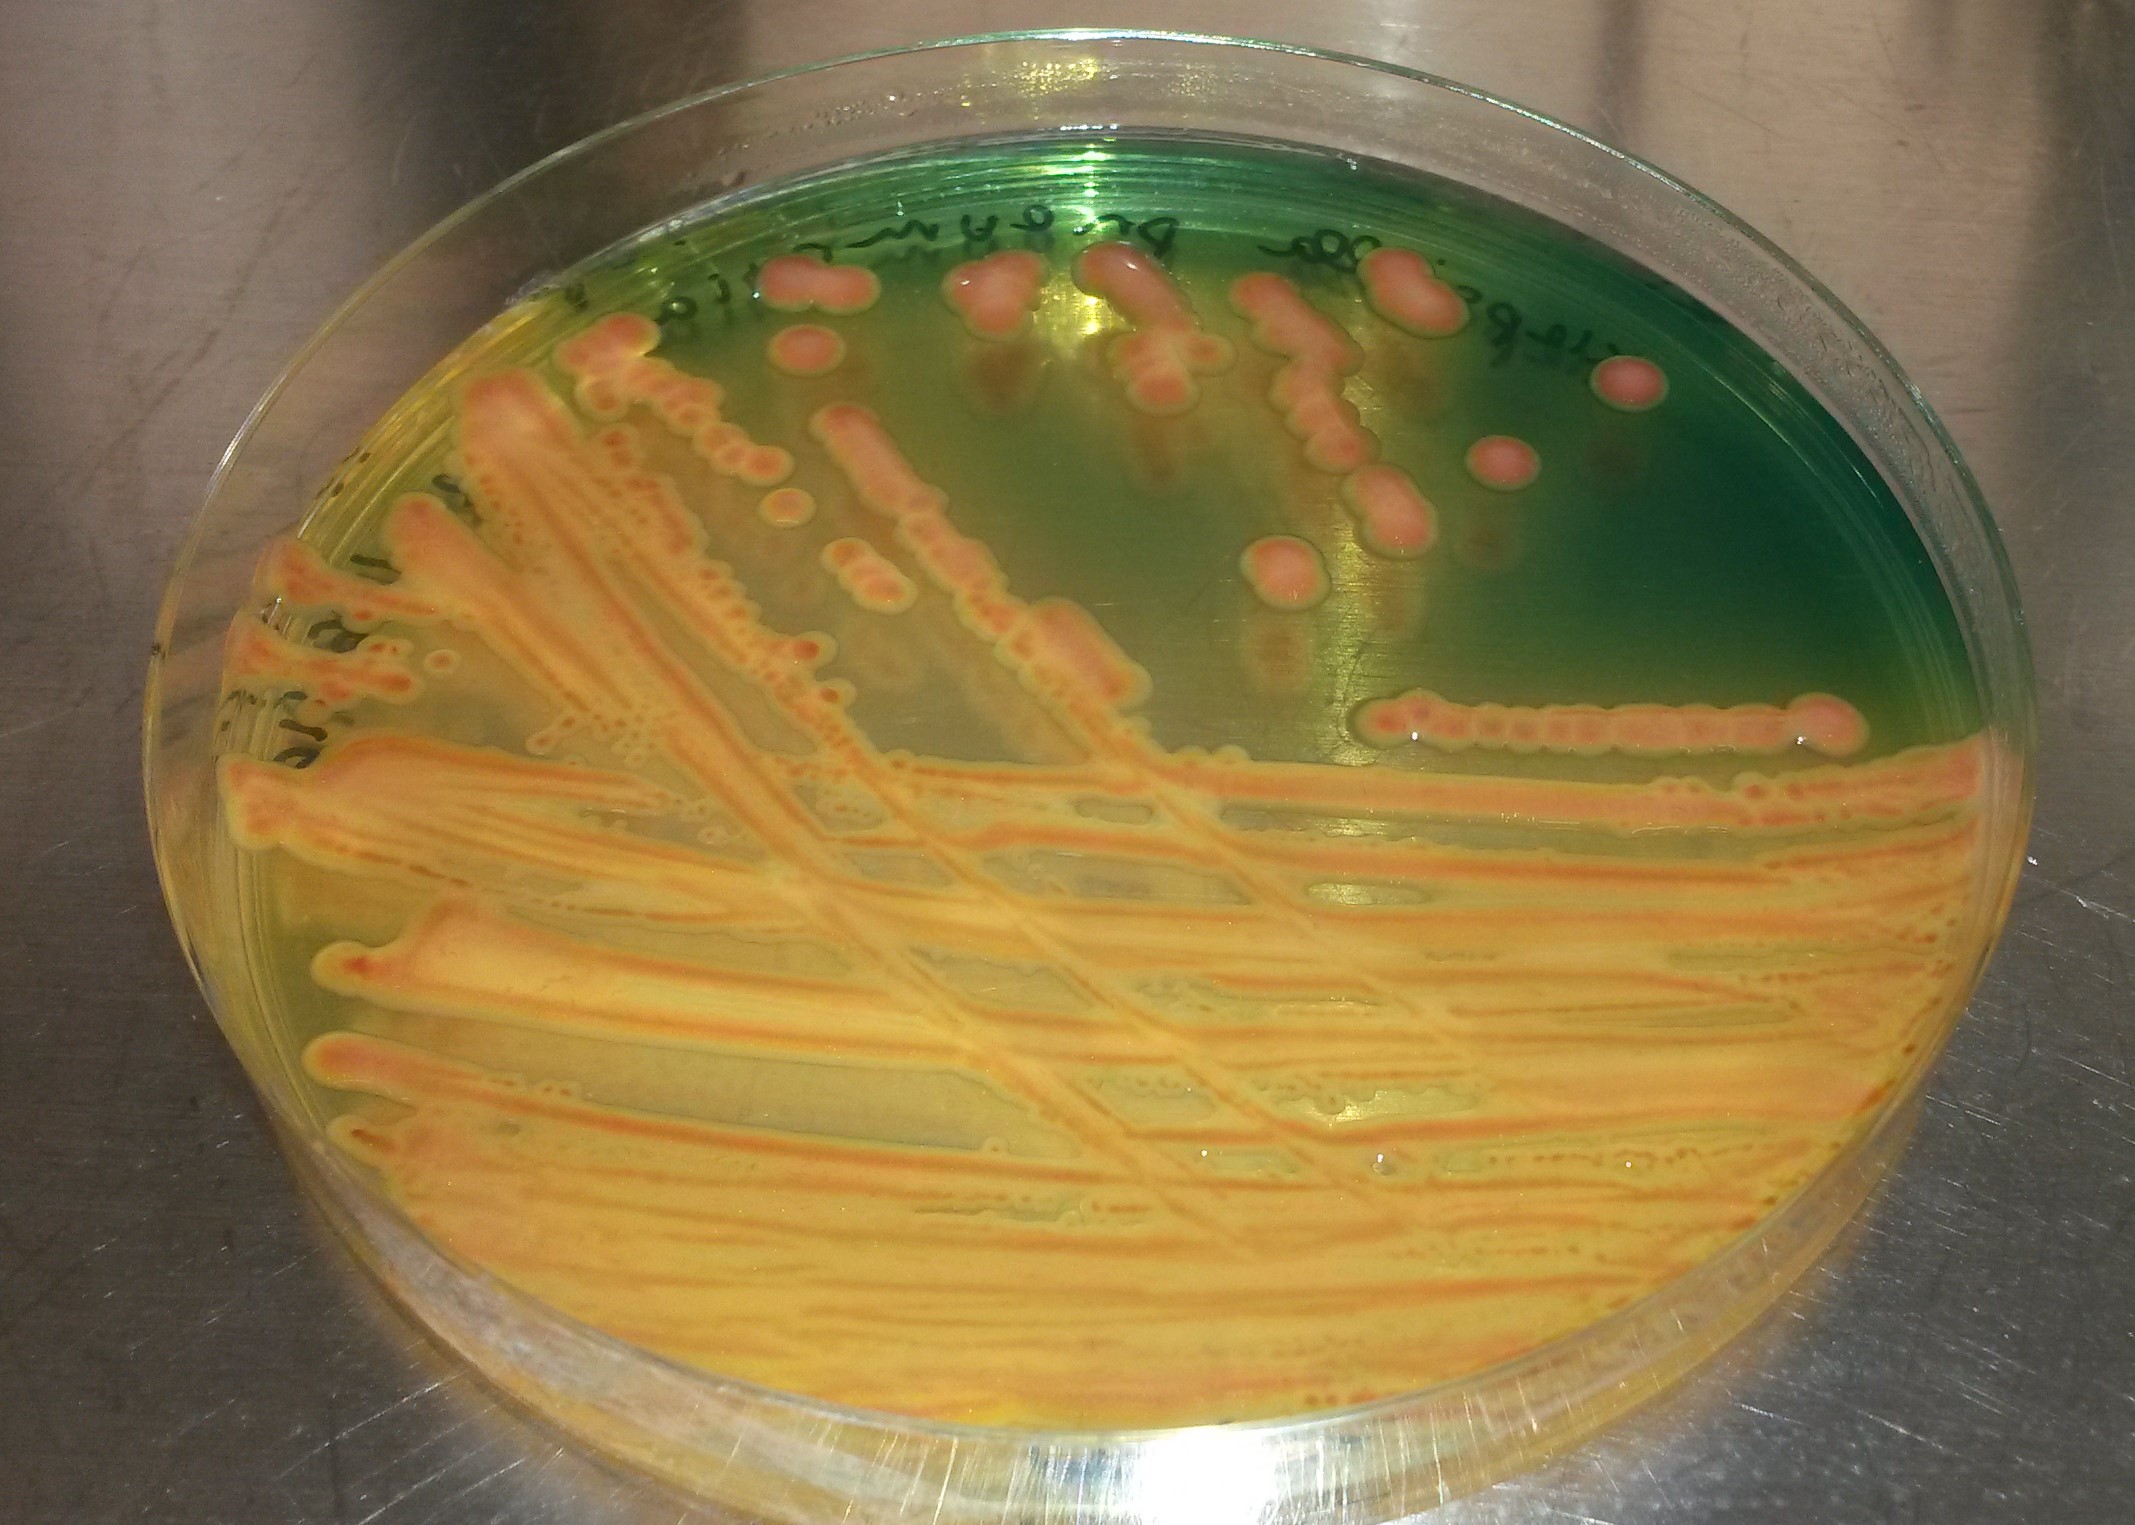

Docteur en Physiologie et biologie des organismes de 31 ans, la jeune femme a remporté le premier prix dans la catégorie « recherche universitaire » lors de la nuit des Luminas 2019. Avec son bac de sciences de l’ingénieur au Lycée du Lorrain, elle poursuit ses études en faisant un BTS bio-analyses et contrôles au lycée de Bellevue, une licence biologie santé au département scientifique inter facultaire (DSI) au Campus de Schoelcher puis part en Guadeloupe pour son master au Campus de Fouillole en Guadeloupe. Attachée à la région qui l’a vue naître la jeune femme démontre qu’il est possible de bénéficier d’une formation de qualité tout en restant aux Antilles.
Questions/Réponses
D’où vient ton intérêt pour les sciences ?
Bien qu’ayant toujours voulu être architecte n’ayant pas été acceptée dans des écoles je me suis orientée vers mon deuxième choix qui était la biologie.
Quand j’étais petite je me suis toujours posé la question de savoir comment des microorganismes microscopiques pouvaient interagir entre eux et avoir des effets néfastes ou bénéfiques sur nous. Ce questionnement a provoqué une vocation et de par mon cursus où j’ai tenu à davantage m’orienter vers la santé humaine, animale et environnementale. Savoir s’il existait un cycle de diffusion entre ces différents compartiments et voir comment améliorer les rapports entre ces derniers.
Revendiquant la possibilité d’avoir un parcours d’excellence aux Antilles, penses-tu avoir toi-même bénéficier d’une telle opportunité?
Je dirais que mon cursus a été en parfaite adéquation de ce que moi j’attendais dans la mesure où je voulais avoir des connaissances et développer des compétences en région tropicale (contexte caribéen oblige). L’avantage que j’ai eu est d’avoir pu suivre pas mal de formations axées sur les micro-organismes tropicaux ainsi que des conférences avec des professionnels à l’Institut National de recherche agronomique (INRA) ou de l’Institut Pasteur de la Guadeloupe notamment. C’étaient des informations concrètes par rapport à la Caraïbe.
De plus étant donné la diversité de la biodiversité Antillaise, je pense que cela était une chance de pouvoir être formée par des chercheurs travaillant dans ce contexte, car ils ont pu nous donner des cas concrets. Si j’étais partie en France j’aurais certaines plus eu d’apport théorique à étudier.
Quel est ton sujet de thèse ?
C’est l’influence des rejets humains et animaux sur la diffusion de l’antibiorésistance à l’homme, aux animaux et à l’environnement. L’objectif majeur de mon travail était de chercher s’il y avait une dissémination de bactéries résistantes aux antibiotiques des excréments compostés (fientes de poules, crottins de chevaux, boues de stations d’épurations), des sols amandés et des légumes (concombres et patates douces) issus de ces cultures. L’idée était de comprendre si nos légumes pouvaient être contaminés avec des bactéries pathogènes pour l’homme et résistantes aux antibiotiques en fonction des excréments que nous utilisons pour notre compost et voir s’il y avait persistance de ces bactéries dans les sols qui pourraient être contaminés.

Antibiogramme
Enterobactérie
Peux-tu donc nous parler des risques sanitaires que nous courrons ?
Nous avons travaillé à partir du compostage industriel d’une entreprise en Guadeloupe et un compostage de particulier (un agriculteur). Nous avons procédé à diverses analyses (microbiologiques et génomiques) pour mesurer la persistance ou non de bactéries résistent aux antibiotiques. Par rapport à nos deux procédés, nous n’avons pas vu de persistance de ces bactéries dans les cultures (sols et légumes).

Néanmoins il faut respecter les pratiques de compostage qui réduise les risques de persistance. Plusieurs facteurs influencent la qualité du compost : une aération régulière des matières organiques (végétaux, excréments,…), une humidification à réajuster si nécessaire et une maturation complète des matières organiques, car le produit finis doit être à température ambiante et friable. Le compostage industriel dure en moyenne 1 mois et celle d’un particulier environ 4 mois.

D’où te vient cet objet de thèse ?
Je dirais qu’il vient de l’équipe de recherche dans laquelle j’ai travaillé quand j’étais technicienne de laboratoire. Durant cette période, une de mes encadrantes travaillait sur une étude qui visait à contrôler les eaux de rejets des stations d’épuration. Des prélèvements ont été effectués en aval et en amont des stations d’épuration et des prélèvements contrôles dans les eaux de rivières ou de mangroves. Et nous avons constaté que les eaux de rivière présentaient des traces des fameuses bactéries. Ils se sont rendu compte qu’un agriculteur jetait directement sont lisier de porc dans la rivière ce qui expliquait les résultats obtenus et nous avons même appris que d’autres agriculteurs épandaient ces excréments directement sur leur sol. Grâce à notre étude, ils sont désormais conscients des risques que cela peut engendrer et de l’existence d’autres techniques, comme le compostage pour valoriser leur déchet en ayant une geste écologique et écoresponsable. Comme exemple de bonne pratique pour 1m³ d’excrément il faut rajouter des déchets verts puis les mettre dans un composteur hermétique ou à l’air libre il faut l’humidifier et au minimum deux fois par mois retourner la motte de composter.
Que penses-tu de la visibilité des travaux produits par les doctorants ?
Il y a de plus en plus d’initiative visant à vulgariser les travaux des jeunes chercheurs comme le concours de la « Science en Pointe » en Guadeloupe. Chaque année à Point-à-Pitres des doctorants sont sélectionnés pour exposer leurs travaux de manière vulgarisée. Cette année il y a eu la première édition du concours de « Ma thèse en 180 secondes » aux Antilles, dont j’ai reçu le prix public. Néanmoins ces initiatives peinent à drainer un nombre conséquent de personnes, mais elles ne font que débuter.
Peux-tu revenir sur ton expérience des Luminas ?
Après avoir soutenue ma thèse en avril 2018, j’essaye de me dépasser en postulant aux différentes initiatives. Je me suis bien rendu compte que celui qui ne tente pas n’a rien. J’étais très heureuse de gagner mais comme je l’ai dit le jour même nous étions tous talentueux, néanmoins ça reconnaît tous les efforts que j’ai fait et le soutient de mes proches. Cela m’a permis d’être plus visible aux Antilles et de nuancer beaucoup l’argument de la rivalité Guadeloupe Martinique parce que 50% de mes votes était guadeloupéens.
As-tu des engagements en dehors de tes travaux de recherche ?
Je me suis révélée après avoir soutenu ma thèse et où j’ai voulu transmettre mes expériences positives ou négatives. C’est pour ça que je suis devenue la présidente de l’association des jeunes chercheurs de Guadeloupe (AJC) depuis février 2019. J’aiguille et aide en me rendant utile d’une autre façon.
Le mot de la fin
Dans la vie, il faut osez, saisir les opportunités qui nous sont offertes, bien des fois le manque de confiance en nous, nous pousse à rester dans notre zone de confort, mais vous verrez que vous n’avez rien à perdre, mais tout à gagner. Peu importe le discours des personnes autour de vous, même s’ils vous dénigrent dites-vous que ce n’est pas une personne qui va vous définir mais seulement vous-même. Donc rester toujours en accord avec votre voix intérieur et vos principes de vie. Et je finirai en vous disant qu’avant de vous engager dans des études longues il faut être conscient qu’il s’agit d’un engagement personnel important qui demande des sacrifices.
Martin Klôwè- Martinique

Laisser un commentaire